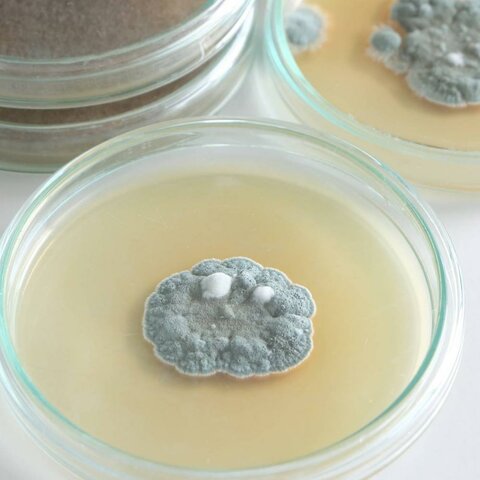
Scoperta della penicillina

-
 Il medico e biologo Karl Ernest Landsteiner individuò 3 dei 4 gruppi sanguigni umani (A, B, 0). Successivamente i suoi collegi Decastello e Sturli scoprirono il gruppo AB.
Il medico e biologo Karl Ernest Landsteiner individuò 3 dei 4 gruppi sanguigni umani (A, B, 0). Successivamente i suoi collegi Decastello e Sturli scoprirono il gruppo AB. -
William Herschel, ufficiale inglese, introduce l'uso dell'impronta digitale del pollice, utilizzandola per i criminali.
-
I fratelli Wright riescono a far funzionare il primo velivolo a motore, sorvolando il cielo di Kitty Hawk, nella Carolina del Nord, per quattro volte.
-
 Il Cellophane fu inventato da Jacques E. Brandenberger, un ingegnere tessile svizzero, che dopo aver rovesciato del vino su una tovaglia, ebbe l'idea di creare un imballaggio trasparente e protettivo.
Il Cellophane fu inventato da Jacques E. Brandenberger, un ingegnere tessile svizzero, che dopo aver rovesciato del vino su una tovaglia, ebbe l'idea di creare un imballaggio trasparente e protettivo. -
 Albert Einstein elaborò e pubblicò la teoria della relatività generale.
Albert Einstein elaborò e pubblicò la teoria della relatività generale. -
 Nel 1916, esordiva il primo prototipo di carro armato, il britannico Mother.
Nel 1916, esordiva il primo prototipo di carro armato, il britannico Mother. -
 John Logie Baird crea la prima televisione e effettua dei test con i due pupazzi “Spooky” e “James”. Gli esperimenti hanno successo.
John Logie Baird crea la prima televisione e effettua dei test con i due pupazzi “Spooky” e “James”. Gli esperimenti hanno successo. -
 L'ingegnere Richard Drew creò un nastro di carta con un lato adesivo che si poteva tirare via lasciando tutto pulito.
L'ingegnere Richard Drew creò un nastro di carta con un lato adesivo che si poteva tirare via lasciando tutto pulito. -
Alexander Fleming, microbiologo inglese, nel suo laboratorio di St. Martin, a Londra, verificando lo stato di una coltura di batteri, vi trovò una copertura di muffa. La cosa eccezionale fu il fatto che questa muffa aveva annientato tutti i Batteri circostanti.
Alexander Fleming, microbiologo inglese, nel suo laboratorio di St. Martin, a Londra, verificando lo stato di una coltura di batteri, vi trovò una copertura di muffa. La cosa eccezionale fu il fatto che questa muffa aveva annientato tutti i Batteri circostanti. -
 A New York, Chester Carlson e il suo assistente, Otto Kornei, riuscirono nell'impresa di replicare il testo di un foglio stampandolo su un altro grazie a un dispositivo elettrofotografico. In sostanza, l'antenato delle odierne fotocopiatrici.
A New York, Chester Carlson e il suo assistente, Otto Kornei, riuscirono nell'impresa di replicare il testo di un foglio stampandolo su un altro grazie a un dispositivo elettrofotografico. In sostanza, l'antenato delle odierne fotocopiatrici. -
 László Bíró, un giornalista ungherese, notò che gli inchiostri usati nella stampa di giornali asciugavano rapidamente, lasciando la carta asciutta e senza sbavature. Decise così di creare una penna utilizzando lo stesso tipo di inchiostro. Bíró si avvalse dell'aiuto del fratello György, un chimico, per sviluppare la formula di un inchiostro viscoso, adatto ad essere utilizzato nella sua penna a sfera.
László Bíró, un giornalista ungherese, notò che gli inchiostri usati nella stampa di giornali asciugavano rapidamente, lasciando la carta asciutta e senza sbavature. Decise così di creare una penna utilizzando lo stesso tipo di inchiostro. Bíró si avvalse dell'aiuto del fratello György, un chimico, per sviluppare la formula di un inchiostro viscoso, adatto ad essere utilizzato nella sua penna a sfera. -
 Julius Robert Oppenheimer, fu chiamato come consulente politico sull’uso dell’energia nucleare. Si giunse alla realizzazione di un prototipo di bomba nucleare (chiamato “Trinity”) che fu testato il 16 Luglio 1945 a Alamogordo, New Mexico.
Julius Robert Oppenheimer, fu chiamato come consulente politico sull’uso dell’energia nucleare. Si giunse alla realizzazione di un prototipo di bomba nucleare (chiamato “Trinity”) che fu testato il 16 Luglio 1945 a Alamogordo, New Mexico. -
 Il primo Transistor (un dispositivo a semiconduttore) fu creato da Walter Brattain e John Bardeen del gruppo di ricerca guidato da William Shockley.
Il primo Transistor (un dispositivo a semiconduttore) fu creato da Walter Brattain e John Bardeen del gruppo di ricerca guidato da William Shockley. -
 Carl Djerassi, giovane chimico, crea la prima pillola anticoncezionale in un laboratorio di Città del Messico.
Carl Djerassi, giovane chimico, crea la prima pillola anticoncezionale in un laboratorio di Città del Messico. -
 I primi esperimenti di trasmissione a colore vera e propria avvennero verso la fine degli anni quaranta negli Stati Uniti. Durante questi esperimenti venne messo a punto quello che poi nel 1953 sarebbe divenuto lo standard NTSC (National Television Systems Commitee).
I primi esperimenti di trasmissione a colore vera e propria avvennero verso la fine degli anni quaranta negli Stati Uniti. Durante questi esperimenti venne messo a punto quello che poi nel 1953 sarebbe divenuto lo standard NTSC (National Television Systems Commitee). -
 Lo Sputnik 1 fu il primo satellite artificiale in orbita della storia. Venne lanciato il 4 ottobre 1957 dal cosmodromo di Baikonur, nell'odierno Kazakistan
Lo Sputnik 1 fu il primo satellite artificiale in orbita della storia. Venne lanciato il 4 ottobre 1957 dal cosmodromo di Baikonur, nell'odierno Kazakistan -
 Douglas Engelbart ideò con altri diciassette colleghi presso l'Augmentation Research Center, il primo prototipo di mouse.
Douglas Engelbart ideò con altri diciassette colleghi presso l'Augmentation Research Center, il primo prototipo di mouse. -
 Roland Moreno, nel 1974, depositò il brevetto per una scheda trasportabile capace di memorizzare e gestire dati.
Roland Moreno, nel 1974, depositò il brevetto per una scheda trasportabile capace di memorizzare e gestire dati. -
 La progettazione del CD (compact disk) nella sua configurazione definitiva risale al 1979 e si deve ad una joint venture della Philips con l'azienda giapponese Sony, la quale già dal 1975 stava sperimentando in modo indipendente la tecnologia per un disco ottico digitale.
La progettazione del CD (compact disk) nella sua configurazione definitiva risale al 1979 e si deve ad una joint venture della Philips con l'azienda giapponese Sony, la quale già dal 1975 stava sperimentando in modo indipendente la tecnologia per un disco ottico digitale. -
 La società fondata da Adam Osborne, nel 1981, lanciò sul mercato l'Osborne I, il primo computer portatile.
La società fondata da Adam Osborne, nel 1981, lanciò sul mercato l'Osborne I, il primo computer portatile.
Want to make a timeline like this?
Use Timetoast to turn dates, events, milestones, and phases into a clear visual timeline you can build and share. Timetoast is a timeline maker for work, school, research, and stories.


